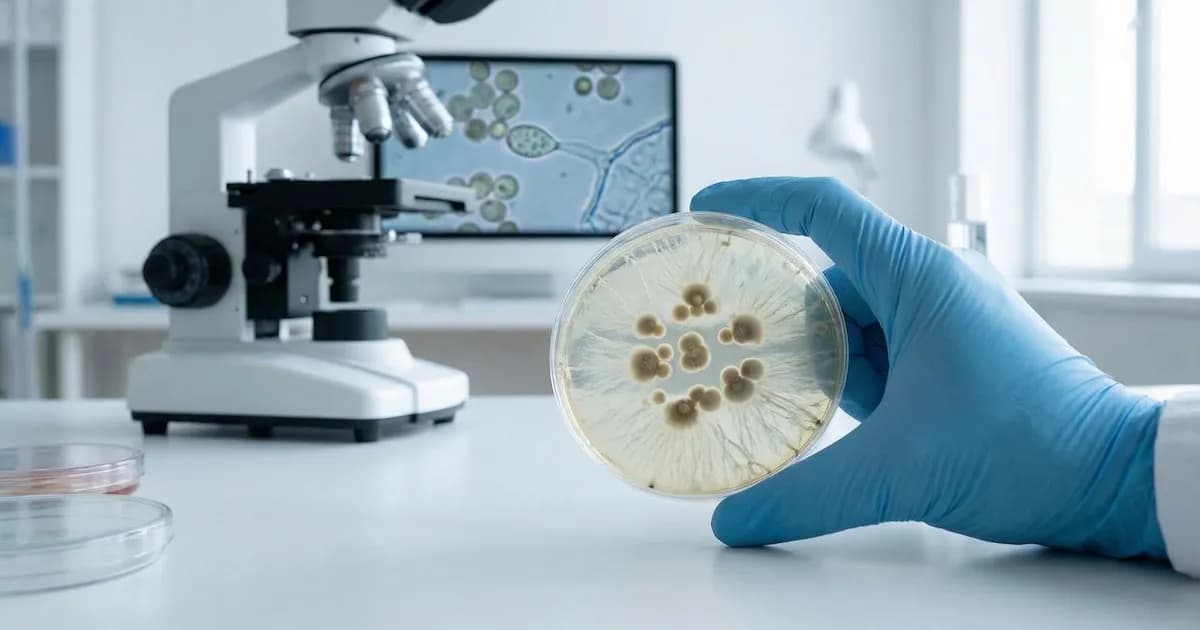
Identifican genes que regulan la agresividad de hongos mortales para humanos

Científicos han descubierto dos genes fundamentales en la agresividad de ciertos hongos, lo que representa un avance significativo en la lucha contra infecciones severas. Un equipo de investigación de la Universidad de Murcia y el Centro de Investigaciones Biológicas Margarita Salas ha identificado los genes dkl y dfl, los cuales son cruciales en la conversión entre las formas de levadura y micelio en hongos del grupo Mucorales.
Este mecanismo es vital para la capacidad de estos hongos de infectar a los humanos y causar enfermedades graves como la mucormicosis. Los genes dkl y dfl actúan como reguladores que controlan tanto la forma infecciosa del hongo como su adaptación a diferentes entornos, lo que abre la puerta a nuevas estrategias para combatir infecciones fúngicas.
Los investigadores se centraron en el hongo Mucor lusitanicus, que sirve como modelo para estudiar la patogenicidad de los Mucorales. Los hallazgos, publicados en la revista Current Biology, indican que la manipulación de los genes dkl y dfl podría ser clave para limitar el desarrollo de infecciones graves, especialmente en personas con sistemas inmunológicos comprometidos. La capacidad de estos hongos para alternar entre sus formas morfológicas les permite sobrevivir en diversas condiciones, lo que aumenta su virulencia y su potencial patogénico en los seres humanos.